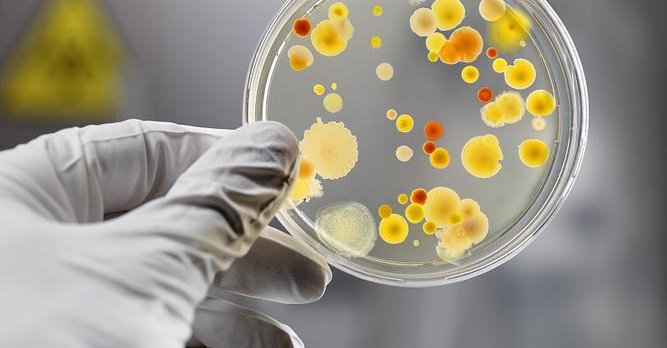

抗菌藥物耐藥性(antimicrobial resistance,AMR)正在成為嚴峻的全球公共衛(wèi)生危機。當(dāng)微生物出現(xiàn) AMR,會導(dǎo)致常規(guī)治療方案失效,感染難以控制,增加疾病和死亡的風(fēng)險,每年有數(shù)十萬人因抗生素耐藥性感染而喪生,若不干預(yù),到2050年這一數(shù)字將突破1000萬。

破解困局的關(guān)鍵,在于發(fā)現(xiàn)和篩選新型耐藥性抗生素。而很多經(jīng)典抗生素,都來自細菌、真菌等微生物的次級代謝產(chǎn)物,為了在細菌中分離出新的化學(xué)物質(zhì),必須在實驗室中培養(yǎng)天然細菌樣品。但這里藏著一個大難題:
人類能夠利用的細菌還不到自然界總量的1%
剩下99%的微生物無法在實驗室中分離和培養(yǎng),它們對生長環(huán)境的要求極為苛刻,例如需要特定的共生菌、特殊的營養(yǎng)物質(zhì)、特定的酸堿度或厭氧環(huán)境等。
Q
如何從微生物中篩選出新型抗生素藥物呢?
科研人員從熱帶雨林土壤、海洋、火山口等極端環(huán)境采樣,在實驗室培養(yǎng)后,檢測其發(fā)酵產(chǎn)物是否具有抑制致病菌的活性,并對其發(fā)酵產(chǎn)物進行純化分離,鑒定最終產(chǎn)物的結(jié)構(gòu)和篩選活性物質(zhì)及機理研究。典型流程如下:

在此過程中,從培養(yǎng)液中提取的代謝產(chǎn)物經(jīng)過固相萃取粗分離、HPLC制備后,成百上千個微量珍貴樣品裝在96孔板/微量離心管里,每一步都會產(chǎn)生大量不同的溶劑。為不影響后續(xù)分析,在進入質(zhì)譜和NMR分析前,必須進行溶劑去除。如果使用常規(guī)的濃縮方式(如氮吹),樣品容易產(chǎn)生交叉污染,樣品容易失活,過度干燥損傷等問題。
TEGENT
Genevac EZ-2 溶劑蒸發(fā)濃縮工作站
精準解決
還好有Genevac EZ-2 溶劑蒸發(fā)濃縮工作站,精準解決這些痛點!Genevac EZ-2溶劑蒸發(fā)濃縮工作站通過減壓和離心的技術(shù),樣品能在低溫下完成溶劑去除,避免高溫破壞活性成分。保護樣品的同時,可以提高高通量篩選過程中的生產(chǎn)力和效率,大大縮短研發(fā)周期。

AMR新藥研發(fā)中,“平穩(wěn)蒸發(fā)”究竟有多重要?主要控制以下關(guān)鍵點:
● 保證樣品完整性
蒸發(fā)是一個非常復(fù)雜的過程,在蒸發(fā)過程中保持這些新型化合物的樣品完整性尤其重要,避免丟失有價值的樣品和重復(fù)實驗。Genevac EZ-2采用Sample Shield®技術(shù)精準控制溫度和壓力,避免樣品過熱,在源頭上保護這些新型化合物的活性。搭配智能蒸發(fā)軟件,自動停機,無需人員值守,避免樣品干燥后持續(xù)加熱,過度干燥可能導(dǎo)致其空間構(gòu)象改變,徹底喪失抗菌活性;
● 提高純度,避免交叉污染
樣品純度不僅指自身成分不失活、不降解,還包括樣品不被污染,蒸發(fā)過程如果控制不好,會導(dǎo)致樣品產(chǎn)生劇烈的暴沸。Genevac的Dri-Pure® 防暴沸技術(shù),通過精準控制蒸發(fā)方式,控制蒸發(fā)僅在溶劑表面進行沸騰。防暴沸帶來的 “平穩(wěn)蒸發(fā)”,不僅能防止樣品交叉污染,還能避免因劇烈沸騰導(dǎo)致活性成分流失,最大限度保留了樣品 “原始的狀態(tài)”;

使用Dri-Pure
未使用Dri-Pure
● 提高生產(chǎn)力和效率
可以多樣品并行濃縮,高篩選通量不卡殼。無需復(fù)雜樣品制備,預(yù)設(shè)程序方法一鍵調(diào)用,無需摸索。甚至能 “過夜自動運行”,白天專注實驗,晚上安心休息,最大限度地提高實驗室的生產(chǎn)力和效率;

如果您對上述產(chǎn)品感興趣,可隨時聯(lián)系德祥科技撥打熱線400-006-9696,或點擊下方鏈接填寫表單咨詢。
Genevac
ATS集團是德祥集團資深合作伙伴之一。英國Genevac公司成立于1990年,隸屬ATS SP Scientific旗下,一直專注于研究和生產(chǎn)各種離心蒸發(fā)濃縮設(shè)備,其產(chǎn)品廣泛應(yīng)用于生命科學(xué)、制藥、化學(xué)、分析等領(lǐng)域。
德祥科技
德祥科技有限公司成立于1992年,總部位于中國香港特別行政區(qū),分別在越南、廣州、上海、北京設(shè)立分公司。主要服務(wù)于大中華區(qū)和亞太地區(qū)——在亞太地區(qū)有27個辦事處和銷售網(wǎng)點,5個維修中心和2個樣機實驗室。
30多年來,德祥一直深耕于科學(xué)儀器行業(yè),主營產(chǎn)品有實驗室分析儀器、工業(yè)檢測儀器及過程控制設(shè)備,致力于為新老客戶提供更完善的解決方案。公司業(yè)務(wù)包含儀器代理,維修售后,實驗室咨詢與規(guī)劃,CRO凍干工藝開發(fā)服務(wù)以及自主產(chǎn)品研發(fā)、生產(chǎn)、銷售、售后。與高校、科研院所、政府機構(gòu)、檢驗機構(gòu)及知名企業(yè)保持密切合作,服務(wù)客戶覆蓋制藥、醫(yī)療、商業(yè)實驗室、工業(yè)、環(huán)保、石化、食品飲料和電子等各個行業(yè)及領(lǐng)域。
2009至2021年間,德祥先后榮獲了“最具影響力經(jīng)銷商”、“年度最佳代理商“、”年度最高銷售獎“等殊榮。我們始終秉承誠信經(jīng)營的理念,致力于成為優(yōu)秀的科學(xué)儀器供應(yīng)商,為此我們從未停止前進的腳步。
我們始終相信,每一天都在使這個世界變得更美好!








